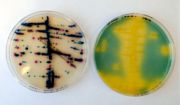
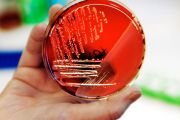
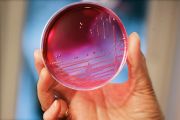

Fillista
Hoppa till navigering
Hoppa till sök
Den här specialsidan visar alla filer som laddats upp.
| Datum | Namn | Miniatyrbild | Storlek (byte) | Användare | Beskrivning | Versioner |
|---|---|---|---|---|---|---|
| 24 mars 2012 kl. 08.01 | P4-tabell.jpg (fil) |  |
374 kbyte | 1 | ||
| 24 mars 2012 kl. 07.47 | P4-bildserie.jpg (fil) | 411 kbyte | P4-laboratoriet på SMI | 1 | ||
| 23 mars 2012 kl. 14.26 | YellowFeverVirus.jpg (fil) |  |
141 kbyte | Gula febernvirus | 1 | |
| 23 mars 2012 kl. 12.59 | Hektoen.jpg (fil) |  |
524 kbyte | Hektoenagar | 1 | |
| 23 mars 2012 kl. 12.31 | Leptospira interrogans strain RGA 01.png (fil) |  |
460 kbyte | Leptospira interrogans | 1 | |
| 23 mars 2012 kl. 12.26 | Smallpox virus.jpg (fil) |  |
87 kbyte | Smittkoppsvirus | 1 | |
| 23 mars 2012 kl. 12.22 | Gram Stain Anthrax.jpg (fil) |  |
41 kbyte | Csv; gramfärgad med Bacillus anthracis | 1 | |
| 23 mars 2012 kl. 12.00 | Ebola virus em.jpg (fil) |  |
568 kbyte | Ebolavirus CDC ID#1833 | 1 | |
| 18 mars 2012 kl. 19.32 | Csmittskydd4OK.jpg (fil) |  |
1,58 Mbyte | Omslagssida Referensmetodik:Smittskyddslagens sjukdomar | 1 | |
| 18 mars 2012 kl. 19.08 | Smittskydd4OK.jpg (fil) |  |
1,66 Mbyte | Omslagsbild till Referensmetodik:Smittskyddslagens sjukdomar | 1 | |
| 18 mars 2012 kl. 13.48 | SmittbildOK1.jpg (fil) |  |
1,6 Mbyte | 1 | ||
| 14 mars 2012 kl. 15.14 | Protozoa Fig3.gif (fil) |  |
9 kbyte | balantidium. Från wiki media commons | 1 | |
| 14 mars 2012 kl. 15.13 | Balantidium trophB.jpg (fil) |  |
12 kbyte | från wiki media commons | 1 | |
| 14 mars 2012 kl. 15.12 | Balantidium coli wet mount.jpg (fil) |  |
305 kbyte | från Wiki media commons | 1 | |
| 14 mars 2012 kl. 13.48 | Cyclospora bild 3 crop.jpg (fil) |  |
39 kbyte | 1 | ||
| 14 mars 2012 kl. 13.47 | Cyclospora Bild 2. 100x.jpg (fil) |  |
233 kbyte | 1 | ||
| 14 mars 2012 kl. 13.43 | Cyclospora crop Bild 1.jpg (fil) |  |
69 kbyte | 1 | ||
| 6 mars 2012 kl. 14.34 | Cyclospora Bild 4 sporulerad oocysta crop.jpg (fil) |  |
36 kbyte | 1 | ||
| 6 mars 2012 kl. 14.29 | Cyclospora Bild 4 sporulerad oocysta.jpeg (fil) |  |
226 kbyte | 1 | ||
| 6 mars 2012 kl. 14.27 | Cyclospora bild 3.jpeg (fil) |  |
157 kbyte | 1 | ||
| 6 mars 2012 kl. 13.32 | Isospora bild 2.jpg (fil) |  |
675 kbyte | OOcysta från Isospora (Cycloisospora) hominis. Foto: Marianne Lebbad SMI | 1 | |
| 26 februari 2012 kl. 09.21 | VerifieringEnterokocker.jpg (fil) |  |
284 kbyte | 1 | ||
| 26 februari 2012 kl. 09.21 | VanAochvanB Rotor-Gene.jpg (fil) |  |
381 kbyte | 1 | ||
| 26 februari 2012 kl. 09.21 | VanAochvanB LightCycler.jpg (fil) |  |
459 kbyte | 1 | ||
| 26 februari 2012 kl. 08.49 | Tabell 4 enterokocker 0001.jpg (fil) |  |
328 kbyte | 1 | ||
| 26 februari 2012 kl. 08.43 | Tabell 4 Enterokocker.jpg (fil) |  |
377 kbyte | 1 | ||
| 19 februari 2012 kl. 09.59 | PFGE-VRE.jpg (fil) |  |
1,85 Mbyte | PFGE-VRE | 1 | |
| 13 februari 2012 kl. 12.20 | CLED.jpg (fil) |  |
270 kbyte | 1 | ||
| 13 februari 2012 kl. 12.02 | Kromagar CLED 2.jpg (fil) |  |
147 kbyte | 1 | ||
| 13 februari 2012 kl. 11.59 | Kromagar CLED.jpg (fil) | |
65 kbyte | 1 | ||
| 29 januari 2012 kl. 10.51 | BKromogentabell.jpg (fil) |  |
147 kbyte | Tabell som jämför kromogent substrat mot referenssubstrat | 1 | |
| 29 januari 2012 kl. 10.47 | Kromogentabell.jpg (fil) |  |
1,44 Mbyte | Tabell som jämför kromogent substrat mot referenssubstrat | 1 | |
| 13 januari 2012 kl. 14.22 | S9K3231.jpg (fil) | |
111 kbyte | Försättssida referensmetodik, Bild SMI | 1 | |
| 13 januari 2012 kl. 14.21 | S9K3426.jpg (fil) | |
95 kbyte | Försättssida referensmetodiken, Bild SMI | 1 | |
| 18 december 2011 kl. 14.52 | Mossel3.jpg (fil) |  |
413 kbyte | Mossels ecometriska metod, bild: Magnus Thore | 1 | |
| 22 september 2011 kl. 12.32 | Skabb. Foto.jpg (fil) |  |
42 kbyte | Foto: Lill-Marie Persson, Kärnsjukhuset i Skövde | 1 | |
| 22 september 2011 kl. 12.30 | Lus Foto CT.jpg (fil) |  |
34 kbyte | CT SMI | 1 | |
| 20 september 2011 kl. 12.08 | H.diminutaÄggML-a.jpg (fil) |  |
283 kbyte | Foto:marianne Lebbad, Smittskyddsinstitutet | 1 | |
| 15 september 2011 kl. 13.16 | H nana eggB. G.dept.publ.health.jpg (fil) |  |
18 kbyte | Georgia Dept. Publ. Health via Wikimedia Commons | 1 | |
| 15 september 2011 kl. 13.14 | H nana adultF. cdc.jpg (fil) |  |
15 kbyte | CDC via Wikimedia Commons | 1 | |
| 14 september 2011 kl. 12.19 | 779px-Dipylidium caninum ovum 1.jpg (fil) |  |
53 kbyte | Foto Joel Mills via Wikimedia Commons | 2 | |
| 8 september 2011 kl. 14.12 | Heterophyes egg.jpg (fil) |  |
64 kbyte | Foto: CDC via Wikimedia Commons | 1 | |
| 8 september 2011 kl. 13.16 | Egg of Fasciola hepatica 08G0041 lores.jpg (fil) |  |
48 kbyte | Foto: CDC via Wikimedia Commons | 1 | |
| 8 september 2011 kl. 13.05 | FasciolaÄggML.jpg (fil) |  |
417 kbyte | Foto: Marianne Lebbad, Smittskyddsinstitutet | 1 | |
| 8 september 2011 kl. 09.16 | S.mansoniÄggAM.jpg (fil) |  |
547 kbyte | Foto: Anders Magnusson, Smittskyddsinstitutet | 1 | |
| 8 september 2011 kl. 09.12 | S.HaemobiumÄggAM.jpg (fil) |  |
673 kbyte | Foto: Anders Magnusson, Smittskyddsinstitutet | 1 | |
| 7 september 2011 kl. 10.20 | Clonorchis sinensis egg 06G0049 jpg lores.jpg (fil) |  |
51 kbyte | Foto: CDC via Wikimedia Commons | 1 | |
| 7 september 2011 kl. 08.19 | ClonorchOpisthÄggBS-a.jpg (fil) |  |
344 kbyte | Foto: Silvia Botero Kleiven, Smittskyddsinstitutet | 1 | |
| 6 september 2011 kl. 13.50 | D dendriticum egg wtmt JCG C.jpg (fil) |  |
29 kbyte | Foto: CDC vie Wikimedia Commons | 1 | |
| 5 september 2011 kl. 12.59 | Naegleria fowleri lifecycle stages rotated.jpg (fil) |  |
77 kbyte | Foto: Wiki media commons | 1 |